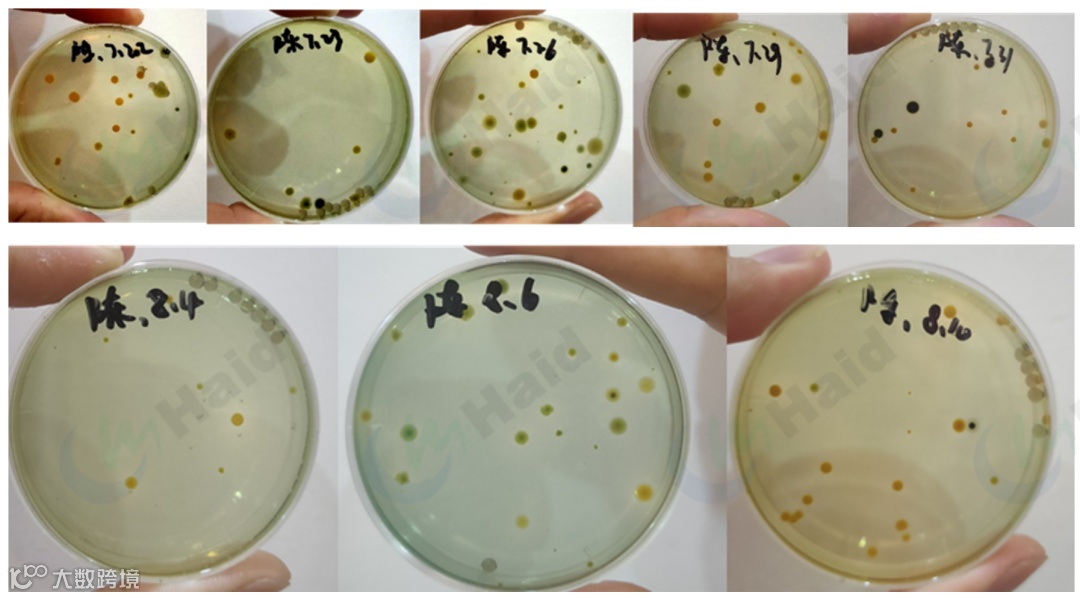

文 | 图 动保事业部 梁乾坤 广州容川 孙会强 袁瑞鹏
如何维持池塘水质稳定,防止水质氨氮亚盐偏高,一直以来都是养殖户比较关注的一个问题,尤其是特种鱼养殖。
每年的5月立夏后水温开始逐渐上升,直到中秋时期水温都一直维持在30℃以上,进入8月份后开始较多降雨,天气变化较大,鱼塘水温变化大,反底、池塘老化、有害菌类爆发问题频发,加上特种鱼高投喂的特点,池塘氨氮亚盐偏高问题逐渐增多,加重了高温期多发病害(诺卡式等)的危害,给养殖户带来很大的损害。
那么海鲈塘高温期稳水为什么这么难呢?
笔者列举了以下几点:
1、传统养殖观念中消杀较多,尤其硫酸铜、甲醛等消毒剂及杀虫剂使用,对于池塘藻类有较大的杀伤性,导致池塘藻类活力受限对氨氮亚盐吸收能力降低,呈现较多黄浊水、浓绿水。
2、海鲈(其他特种鱼品种同样)头批养殖客户追求长速、高投喂池塘中较多有机质积累,导致指标居高不下。
3、部分塘口单一藻相、有害藻类爆发,酱油水。进入8月份后天气剧烈变化倒藻,使池塘水质恶化,指标飙升。
高温期稳水稳指标
尖酵+3101+浊水清效果好
经过广州容川业务团队大量塘口验证发现,尖酵+3101配合浊水清长效改善水色、稳定水质指标有非常理想的效果。

01
案例 一
客户呀哥大塘(海鲈中批)6月份开始使用尖酵+3101,20亩水体,前两周每周两次尖酵+3次101(每次2包尖酵+4包101),后续每周一次尖酵+2次101,使用1个月后,后续搭配浊水清使用(2-3天1包)。
产品使用期间,水色一直保持清爽嫩绿。

包括进入8月份,台风侵扰,降雨增多,仍保持较好水色。水质稳定,持续时间达三个月,期间氨氮0.2以内,亚盐控制在0.1以内。

即便8月下旬和9月中上旬珠海天气多变,降雨较多,依然保持嫩绿的优良水色。

指标维持在较低水平。

对养殖过程中的嗜水气单胞菌进行检测,使用过程中嗜水气单胞菌一直维持较好,8月后受天气多变影响略有回升,但整体仍处于较低水平。对游水次数进行检测,6-8月未发生游水,日死鱼量控制在5条以内。

除因台风和杀虫、消毒有停料情况外,整体投料增长较稳定。

02
案例 二
李老板小塘(海鲈头批)用法用量:14亩水体,前两周每周两次尖酵+3次101(每次1包尖酵+3包101),后续每周一次尖酵+2次101,搭配浊水清使用,5万鱼进入高温期后日投喂稳定在12包左右。

水色由黄浊水调节为嫩绿水,并持续保持清爽嫩绿。

水质指标稳定,维持氨氮0.2以内,亚盐0.15以内。维持时间达3个月,期间未发生游水情况。
03
案例 三
客户陈叔塘口:水体浑浊6月底开始出现亚盐偏高,改底增氧后亚盐降低但一周左右又会再次反弹。后续采用尖酵+3101+浊水清。
具体用法:22亩水体,前两周每周2次尖酵+3次101(每次2包尖酵+4包101),后续每周一次尖酵+2次101,搭配浊水清使用。7.21-2.23连续三天使用底倍健+粒粒氧改底配合换水。后续使用尖酵+3101方案。

水质持续保持稳定,亚盐稳定超客户预期。

对其池塘嗜水气单胞菌进行检测:
转化为数字后,可以看出:

强改底氧化后再次补尖酵+3101,可以达到更强更持久的抑菌效果,因此建议广大养殖户朋友在改底增氧或消毒后第二天使用该方案效果更佳。
小结:
广州容川团队对市面上使用尖酵+3101+浊水清塘口使用效果进行统计得出结论:此方案对于改善浊水塘水色,稳定水质指标具有较好的效果和成功率并得到了广大养殖户的高度认可。

效果分析:
尖酵中具有12种特定菌株,每1g就含有40亿菌体,菌株高效协同,定期使用可以有效控制池塘氨氮亚盐等有害物质含量,富含丰富碳源调节池塘碳氮比,配合3101使用,可以长效稳定池塘藻类生长,调节菌藻平衡,提高池塘非蛋白氮(氨氮、亚硝酸盐)转化为可利用蛋白效率,抑制池塘有害菌含量、提高池塘溶氧。

展望:
进入9月后气温开始逐渐下降,对于需要越冬的特种鱼养殖塘口来说,为了预防接下来要到来的水霉、烂身病,需要我们尽快进行肥水、调节池塘指标在较低的范围内,尖酵+3101赶紧用起来吧!
海大农牧
接地气的水产一线技术
长摁二维码,即刻关注




